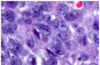
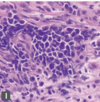

Histology Basics Flashcards
Features of Acute Inflammation (5)
● Vascular congestion
● Edema
● Fibrinous exudate
● Tissue damage and/or necrosis
● Neutrophils (or polymorphonuclear leukocytes, often shortened to “polys”)
Features of Chronic Inflammation
● Increased vascularity and/or fibrosis (attempts to heal)
● Tissue destruction or obliteration of normal structures
● Lymphocytes, macrophages*, plasma cells, eosinophils
Acanthosis
thickening of the epithelium, usually referring to a keratinized epidermis.
Hyperkeratosis
too much keratin, which sits on the epithelial surface in a thick pink layer, often accompanied by parakeratosis.
Orthokeratosis
“normal” anucleate keratin, found on the skin, with a basket weave pattern.
Parakeratosis
the retention of small pyknotic nuclei in surface keratin
Papilloma
exophytic growth of finger-like, arborizing projections with fibrovascular cores, lined by squamous epithelium

Pseudoepitheliomatous hyperplasia:
a benign reactive condition that simulates invasive squamous cell carcinoma. It has a very characteristic look, as though someone dragged the epithelium down into the stroma with a toothpick, like marbling a cake. The individual nuclei should look reactive, not dysplastic. There should not be deep keratinization. Granular cell tumors are notorious for provoking an intense pseudoepitheliomatous reaction.

Verrucous
warty; an exophytic growth pattern with prominent hyperkeratosis and an appearance described as “church spire” (pointy projections) or “cauliflower” (rounded projections).

Alveolar
resembling alveoli or little cells, sacs, or nests; Nested—there is structure to the lesion but no glands or ducts

Basaloid:
resembling basal cell carcinoma; A blue, nested tumor (often poorly differentiated squamous) with tightly packed nuclei and palisading

Biphasic
having components of two cell lineages; Spindled cells with islands of epithelial cells or glands
Cribriform
perforated, like a colander; Crisp round holes within a glandular structure

Chicken wire
branching, anastamosing network of vessels

Discohesive
falling apart into single cells; No common borders among cells

Epithelioid:
composed of round to oval cells with abundant cytoplasm; Cells look plump and have clear cell borders; the opposite of sarcomatoid

Fascicular:
composed of fascicles Bundles of elongated, spindly cells streaming in parallel arrays

Glandular:
forming gland structures with lumens True glands should have polarized cells radiating around a lumen

Festoon-like/Garland-like
undulating appearance

Filigree-like
complex, interwining threads

Geographic necrosis
large confluent areas of necrosis with an irregular outline

Glomeruloid:
resembling the glomerulus; A coiled tangle of vessels, capillaries, or glands

Herringbone:
resembling a pattern of tweed fabric; A variant of fascicular that shows bundles alternating in a zigzag array

Hobnailed:
resembling a large-headed nail once used in shoes; Epithelial or endothelial cells that round up and protrude into the lumen as little humps